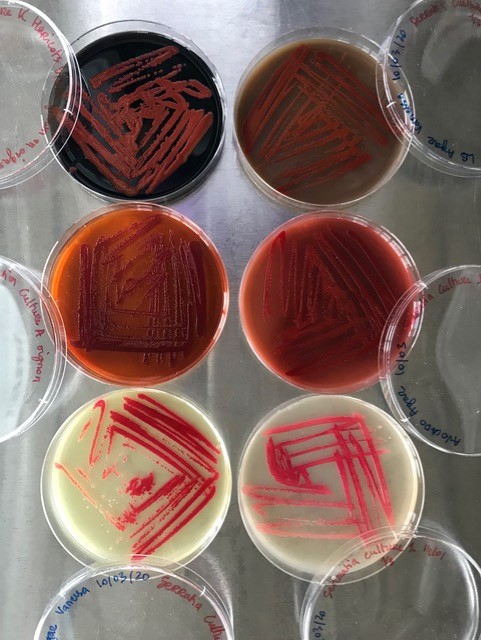

After winning the Concordia round of the MT180 competition back in June, BioLaber Vanessa Mardirossian is now moving on to the final this Thursday. Like the first round, she’ll be presenting her PhD thesis in three minutes in a concise and accessible format, but this time she’ll be competing against 15 other Canadian universities.

If you missed her presentation back in the summer, now is your chance to hear her talk about her doctoral research on the potential impact of sustainable and bacterial dyes in the fashion and textile industry: La face cachée de la matière: une écolittératie du vêtement par une approche moléculaire de la couleur dans une practique écoresponsable du design textile.
Come support her this Thursday from 3:30 pm to 5:30 pm EST on Facebook Live. Four prizes will be awarded after the presentations and you’ll have 15 minutes to vote for your favourite at the end. For more information about the event, including the live streaming link, check out the Facebook event page. The event can also be streamed on LinkedIn.

Photos provided by Vanessa Mardirossian.
